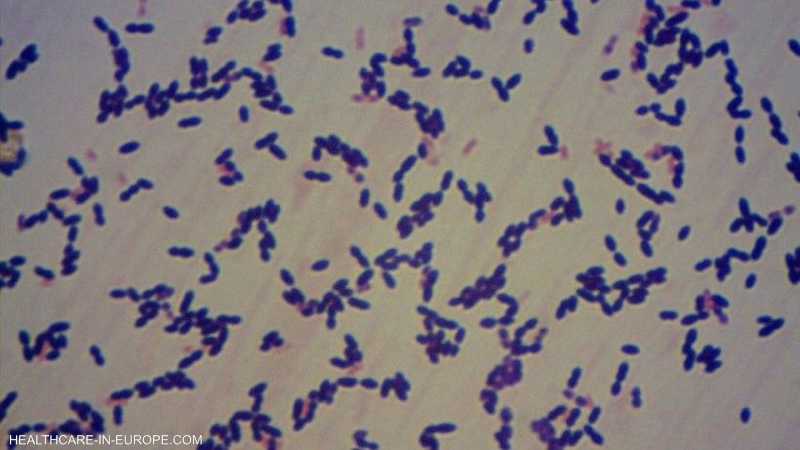

بقلم عبدالرحمن الكردوسي
تحذير خبراء الصحة يابانيين من تفشي عدوى بكتيرية نادرة وخطيرة في جميع أنحاء البلاد يثير المخاوف، حيث تتزايد الحالات بشكل غير مسبوق وتسجل أرقاماً قياسية. يعتقد الخبراء أن البكتيريا المكورات العقدية (Streptococcal) النوع الأشد والأكثر فتكًا من البكتيريا العقدية هي المسبب الرئيسي لهذه الحالات.
وفقًا للمعهد الوطني للأمراض المعدية في اليابان، لا تزال هناك العديد من العوامل غير المعروفة التي تؤدي إلى انتشار هذه البكتيريا بشكل سريع وواسع، وتبقى المرحلة الحالية من البحث لمعرفة الأسباب والمسببات قيد المتابعة.
وتشير الإحصائيات التي نشرها المعهد الوطني للحساسية والأمراض المعدية إلى أنه تم تسجيل 941 حالة إصابة بالبكتيريا العقدية خلال العام الماضي، ومع بداية عام 2024، تم تسجيل 378 حالة إصابة في الشهرين الأولين فقط، مع انتشار العدوى في جميع محافظات اليابان البالغ عددها 47، بإستثناء اثنتين فقط.
وتشير التقارير المحلية إلى أن السلالة الأشد والأكثر فتكًا من بكتيريا المكورات العقدية، المعروفة بـ “المجموعة أ”، تتسبب في المزيد من الوفيات بين المصابين الذين تقل أعمارهم عن 50 عامًا، وتشير الإحصائيات إلى وجود حالات وفاة تشكل حوالي ثلث الحالات في هذه الفئة العمرية.
من ناحية أخرى، يُذكر أن البكتيريا المكورات العقدية تنتقل عن طريق الرذاذ والاتصال الجسدي، وقد تنتقل أيضًا من خلال الجروح، ومن المعروف أنها قد تسبب التهاب الحلق، خاصةً لدى الأطفال، وفي حالات نادرة، يمكن أن تتفاقم الأعراض لتشمل التهاب الحلق واللوزتين والتهاب الرئتين والتهاب السحايا. في الحالات الأكثر خطورة، يمكن أن تتسبب العدوى في فشل الأعضاء.
ويُشدد الخبراءعلى ضرورة اتخاذ إجراءات وقائية للحد من انتشار البكتيريا العقدية في اليابان. تشمل هذه الإجراءات تعزيز النظافة الشخصية وغسل اليدين بانتظام، وتغطية الفم والأنف عند السعال والعطس، وتجنب مشاركة الأدوات الشخصية مع الآخرين، وتعزيز نظام المناعة من خلال التطعيمات المناسبة.
وتعمل السلطات الصحية اليابانية على تعزيز جهود البحث لتحديد أسباب ومسببات هذا التفشي المقلق، يتم تنسيق الجهود بين المعاهد البحثية والمستشفيات ووزارة الصحة، ويتم توجيه الموارد اللازمة للتحقيق في هذه الحالات وتطوير استراتيجيات فعالة للسيطرة على العدوى.
على الرغم من التحذيرات والتدابير الوقائية، يعد الانتشار المستمر للبكتيريا العقدية في اليابان تحديًا صحيًا جديًا يتطلب اهتمامًا فوريًا وتعاونًا وثيقًا بين السلطات الصحية والجمهور، تعزز السلطات الصحية الوعي بالمخاطر المحتملة وتوفر المعلومات اللازمة للجمهور للمساهمة في الحد من انتشار العدوى والحفاظ على صحة المجتمع.